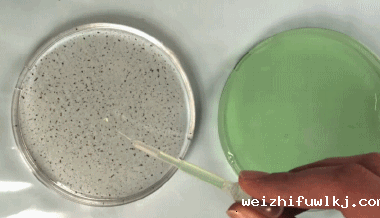

合作客户/
拜耳公司 |
同济大学 |
联合大学 |
美国保洁 |
美国强生 |
瑞士罗氏 |
相关新闻Info
-
> 不同助剂及浓度对IDK120-025型和LU120-015型喷头雾化效果的影响(三)
> NaOL、HZ组合捕收剂对锂辉石矿物浮选效果、表面张力影响(二)
> 双子型起泡剂ULT-1的分子结构式、表面张力、抗温/抗盐性能及煤样润湿性变化——结果与讨论、结论
> 全自动表面18luck国际无法启动、读数不稳定等常见故障及解决方法
> 镀锡板与涂料的表面张力不匹配导致印铁缩孔,怎么解决?
> 不同温度下水波波速和表面张力系数的关系与计算方法【实验】(一)
> 便携式表面18luck国际和气泡压力法表面张力计介绍
> 硝磺草酮悬浮剂制剂不同稀释倍数的动态表面张力测定结果
> GA、WPI和T80复合乳液体系的脂肪消化动力学曲线、界面张力变化(二)
> 结合药液表面张力与苹果树冠层参数预测喷雾药液用量的方法及应用
推荐新闻Info
-
> 耐擦刮无胶消光膜制备方法、高表面张力与收解卷顺畅性的平衡(二)
> 耐擦刮无胶消光膜制备方法、高表面张力与收解卷顺畅性的平衡(一)
> 利用超微量天平制备微孔淀粉处理含Cu(II)离子染料废水
> 不同类型的碱、pH值对孤东油田原油界面张力的影响(下)
> 不同类型的碱、pH值对孤东油田原油界面张力的影响(上)
> 不同结晶结构的脂肪晶体颗粒界面自组装行为、储藏稳定性研究
> 新型POSS基杂化泡沫稳定剂表面张力测定及对泡沫压缩性能的影响(三)
> 新型POSS基杂化泡沫稳定剂表面张力测定及对泡沫压缩性能的影响(二)
188新利app
> 多功能膜材研发:界面张力已成为整套工艺链协同下动态演化的核心控制点
表面张力能怎么玩?下面就是一些常见的小实验方案~
来源:果壳 浏览 2582 次 发布时间:2021-06-15
表面张力能怎么玩?下面就是一些常见的小实验方案~
小物体漂浮之表面张力
把硬币、曲别针、缝衣针之类的东西小心翼翼地放在水面上,可以让它们漂浮起来:

说起来似乎很简单,不过实际操作也是需要一些技巧的,像硬币随随便便放上去就很难成功,可以做一个小的支架把它平着慢慢放到水面上。总之一定要小心操作。
在这里托起小物体的不是浮力,这些金属小物件的密度都比水大,如果浸入水中就沉底了。这里关键的作用力被称为弯曲液面的附加压力,实质上就是表面张力的结果。小物体会向下压水面,在局部形成一个小小的下凹液面,而水的表面张力比较大,它会形成回缩的趋势,在下凹的弯曲液面上,回缩的趋势会产生一种向上的力,就是这个力对抗重力。物体越小,这个作用会越明显,太大的物体就不行了。
牛奶、色素&胡椒粉之表面张力

液体食品色素滴在牛奶上,然后把蘸了洗洁精的棉签杵进去,欣赏食品色素的流动。
这个是Marangoni效应的体现,其实就是表面张力变化造成液体流动的现象。中间加了洗洁精的表面活性剂之后局部表面张力变小,外面的表面张力大,所以我们看到一个表面液体向外流动的趋势。
当然,其实没有食品色素,或者说不想用牛奶也完全没关系。只要有水,有洗涤剂,然后再有一种能够体现液体流动的东西就行了。比如说可以在水的表面撒胡椒粉:
只不过就是色彩没有那么丰富。
酒之泪之表面张力
酒类的挂杯现象,这个直接观察会显得有点慢,比较适合加速观赏。把有一定度数的酒(或者纯粹就是酒精溶液也可以)倒在容器里,晃一晃让壁上均匀沾上一层,然后静置观察。

色素染色看得比较清楚。这种现象出现主要是和液膜中酒精的挥发较快有关,其实还是Marangoni效应的体现。
首先,晃杯子的时候,玻璃杯壁上会形成薄薄的酒溶液薄膜,然后接下来,液膜会逐渐挥发。酒精比水更容易挥发,所以挥发了之后,酒精浓度会下降,而相比集中在杯子下面的酒,液膜的部分因为表面积大,挥发得更快,所以这里酒精浓度下降得也就更明显。而酒精和水造成的表面张力不同,酒精浓度高的地方表面张力更低,而水多的部分表面张力更高一些。液体会从低表面张力的地方被“拉”向高表面张力的地方,所以液膜的上边界并没有往下退,反而是液滴聚集到了上面。同样是在表面张力的作用下,随着酒精的挥发,剩余的液膜也逐渐聚拢成了液滴,接下来它们又在重力的作用下慢慢聚集并流下来,也就成了眼泪的样子。
洗洁精开船之表面张力
这个实验也是很多版本,比如说我小时候看到的版本是做一个小纸船然后在尾巴的地方弄一小块肥皂。不过这里我就想着重介绍一下下面这个超级简单版:把固定面包袋子的那种塑料片摘下了,漂在水面上,然后在小洞的位置滴一滴洗洁精溶液,小船就动起来了。

简直是懒人实验的典范……这个依然是表面张力改变造成的液体流动,带动了“小船”。
吹泡泡
毕竟是表面活性剂作用的一个极好的体现嘛……完全可以把它看成一个表面张力实验!
而且还可以追加玩法,比如说戴上手套来颠泡泡球:

戴上手套能把泡泡一次又一次地弹起来,这一方面是因为干净的手套杜绝了泡泡与人手上油脂的接触,避免油脂改变泡泡膜的表面张力,导致泡泡破裂;另一方面也是因为纤维织物表面孔隙较多,和泡泡的接触面积小,所以也不容易附着。
追逐液滴之表面张力
这个难度比较高,不过现象非常有意思。在这里使用的是含有丙二醇和水的液体食品色素,这些液滴经过不同程度的稀释。在非常洁净的玻璃片上,它们因为蒸发而产生表面张力的变化,从而出现彼此“追逐”的现象。详情:
http://www.guokr.com/article/441058/


虽然看起来比较复杂,不过在科学美国人的Bring Science Home栏目里也能找到教程,有兴趣也不妨一试
~https://www.scientificamerican.com/article/dancing-droplets/
漂浮水球之表面张力
这个一般人没有机会玩了……因为表面张力是一种不依赖重力的作用,所以在太空中,经常会作为演示小实验的主题出现,比如说看着一大团缩成球状的水漂浮在太空舱里。
下面这个就是一个太空水球,放了一个泡腾片进去:

在太空中乱飘的液体也是会有麻烦的,那么做完这些演示之后的水怎么办呢?其实用纸巾或者毛巾吸掉就可以了,因为纸巾吸水的原理毛细现象其实也是表面张力以及弯曲液面附加压力的体现,所以它们在太空中也一样会很顺利地进行~





